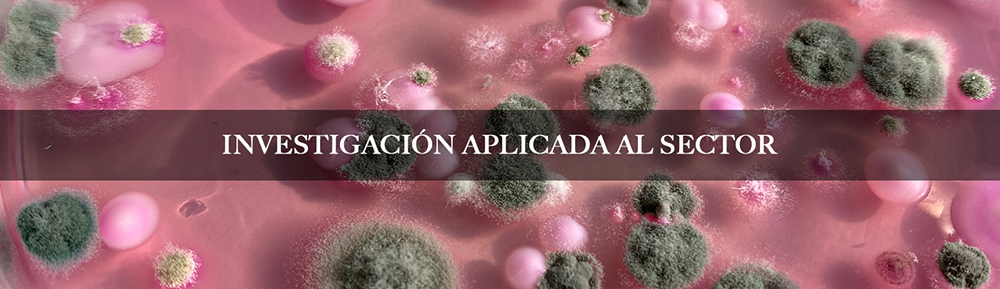

ESNEKI ZENTROA, COMPAÑERO DE VIAJE DEL SECTOR LÁCTEO “Nuestra leche, nuestros productores, nuestra salud”
El centro lácteo Esneki Zentroa impulsa el desarrollo integral del sector lácteo, actuando como motor de innovación y progreso. Combinando la investigación aplicada, el desarrollo de productos innovadores y la transferencia de conocimiento especializado, damos una respuesta eficaz a los retos y necesidades del sector. Bajo el lema “Nuestra leche, nuestros productores, nuestra salud”, nuestro objetivo es la construcción conjunta de un sector lácteo fuerte, sostenible y competitivo. En los últimos años, el sector lácteo de Euskadi ha evolucionado de forma significativa, desde una producción basada en el modelo artesanal, demostrando su capacidad para afrontar nuevos retos.
El sector está gestionado principalmente por unidades familiares y más del 95% está formado por micro queserías. Los productores asumen no sólo la producción de leche, sino también los procesos de transformación para aportar valor añadido a los productos y ser competitivos en el mercado.
Sin embargo, los modelos artesanos plantean varios retos: recursos económicos limitados, difícil implantación de las nuevas tecnologías, dificultades para el acceso al conocimiento tecnológico y la diversificación, etc. Además, la estricta normativa higiénico-sanitaria y la necesidad de gestionar complejos procesos de comercialización ha incrementado la necesidad de asesoramiento tecnológico externo.
Para hacer frente a todos estos retos y tras 15 años de andadura, en el año 2021 se creó ESNEKI ZENTROA como marca, bajo la batuta del Centro Tecnológico Leartiker, con el objetivo de seguir respondiendo a las necesidades del sector. El objetivo del centro lácteo Esneki Zentroa es fortalecer y servir de referente al sector lácteo, combinando investigación, innovación y conocimiento técnico, para impulsar la calidad, seguridad, sostenibilidad y competitividad de la producción artesanal. En Esneki Zentroa trabajamos con un enfoque integral, desde la mejora de la calidad de la leche hasta la comercialización de productos lácteos y quesos, interviniendo en todos los procesos. Somos compañeros de viaje de productores lácteos y queserías, desde su fundación hasta la fase de estabilización, aportando conocimiento y apoyo técnico en los diferentes ámbitos.
En los últimos años hemos desarrollado importantes trabajos de investigación en materia de seguridad alimentaria y tecnología de la leche y productos lácteos. Estas son las diferentes líneas de trabajo de investigación que pueden destacarse (https://esnekizentroa.eus/es/proyectos /):
Investigación relacionada con la seguridad alimentaria:
Hemos desarrollado diversos proyectos relacionados con la investigación de riesgos microbiológicos y químicos asociados a la seguridad de la leche y los productos lácteos, entre otros:SHIGA: estudio genético de diferentes cepas Escherichia Coli con capacidad de producción de toxina Shiga.
ELAMINA-2: Valoración de distintas estrategias para la eliminación de las aminas biógenas presentes quesos que sufren grados elevados de proteólisis en su elaboración y maduración.
EZtaphTox: Genes reguladores y factores desencadenantes de la producción de enterotoxinas en S. aureus en alimentos.
GAZTANOLA: Investigación dirigida a la obtención de evidencias aplicables en el proceso de solicitud de uso de baldas de madera para afinado de quesos.
Investigación de la capacidad tecnológica de la leche:
Investigamos sobre las características microbiológicas y fisicoquímicas de la leche, analizando la capacidad tecnológica de la misma para la elaboración de quesos y realizando la adaptación de los procesos productivos con el objetivo de desarrollar quesos de calidad diferenciada. En los últimos años se han desarrollado en este ámbito, entre otros, los siguientes proyectos:
MILKSUIT: Adaptación de prácticas de alimentación y gestión ganadera para la producción de leche apta para la producción de queso.
DAIRITAL: Desarrollo de sistemas de producción sostenibles en el sector lácteo tradicional del área SUDOE.
ESNEKAL: Estudio de la calidad microbiológica y proteica de la leche cruda de oveja y de cabra para la prevención de problemas tecnológicos en la producción de quesos.
PROTEBAL: Estudio de la fracción proteica y la flora láctica indígena de la leche cruda como factor de calidad y tipicidad en las queserías artesanales de la CAPV.
Investigación en tecnología láctea y quesera y técnicas de afinado:
Desarrollamos proyectos que integran la investigación sobre los parámetros tecnológicos que influyen en la producción de productos lácteos, así como sobre las distintas técnicas de afinado aplicadas a las diferentes familias de quesos, como, por ejemplo:
BEHITEK: Desarrollo de quesos innovadores de leche de vaca de calidad diferenciada.
ONDTEK: Validación del proceso de producción del queso curado de oveja mediante la parametrización de los valores fisicoquímicos de referencia.
GAZTAKAL: Estudio de los parámetros tecnológicos de producción en las diferentes tecnologías queseras como control de calidad del proceso de elaboración y de afinado.
BLUECARE: Introducción de tecnologías numéricas y mediante sensores para el control de producción y de afinado de un queso azul de calidad organoléptica diferenciada seguro, saludable y sostenible.
Los resultados de los diferentes proyectos desarrollados han sido transferidos a los agentes del sector a través de diferentes canales, entre ellos, sesiones formativas, asesoramiento técnico y documentación especializada. Este proceso de transferencia ha permitido llevar a la práctica los resultados de la investigación con el objetivo de influir en la actividad diaria del sector. Por otro lado, los proyectos de investigación relacionados con la seguridad alimentaria se han desarrollado en estrecha colaboración con Elika Fundazioa y la Mesa de Seguridad Alimentaria del Gobierno Vasco para ofrecer una respuesta eficaz y coordinada a las necesidades del sector.
Además de desarrollar la investigación aplicada para dar respuesta a las necesidades del sector, también actuamos en otros ámbitos relevantes con el objetivo de promover el desarrollo integral del sector.

Ayudamos a las queserías en su día a día, a través del asesoramiento permanente, en los procesos de elaboración, en la aplicación de las normativas higiénico-sanitarias vigentes y en la adaptación del etiquetado a la normativa de información al consumidor. Nuestro servicio incluye:
- Asesoramiento en la creación de una nueva quesería: diseño del espacio, necesidades de equipamiento e intermediación con el Departamento de Salud.
- Adecuación y optimización de los procesos de elaboración.
- Identificación de posibles defectos en la producción de quesos y adaptaciones para evitarlos.
- Gestión de la seguridad alimentaria.
- Desarrollo, implantación y seguimiento anual de los planes de autocontrol.
- Definición de los planes de acción tras las auditorías del Departamento de Salud.
- Análisis de leche, productos lácteos y superficies, e interpretación de los resultados.
- Asesoramiento ante incidencias e implantación de medidas correctoras.

Ofrecemos formación especializada dirigida al sector lácteo con el objetivo de profundizar en la competencia técnica y el conocimiento de los productores. Nuestra oferta formativa abarca las siguientes áreas:
- Calidad de leche y productos lácteos
- Primera aproximación a la tecnología quesera
- Elaboración de diferentes productos lácteos frescos
- Elaboración de diferentes categorías de queso
- Afinado de quesos (en colaboración con MONS Formation)
- Comercialización de quesos (en colaboración con MONS Formation)
- MONS Experience (en colaboración con MONS Formation)
El sector lácteo se enfrenta a numerosos retos, pero también a oportunidades únicas. La producción basada en el modelo artesanal aporta diferenciación y calidad, y los agentes del sector demuestran cada día su capacidad de innovación y mejora continua.
El centro lácteo Esneki Zentroa está aquí para acompañar al sector como socio tecnológico en su desarrollo. Juntos, combinando innovación, conocimiento y calidad, seguiremos construyendo un sector lácteo fuerte, sostenible y competitivo.

